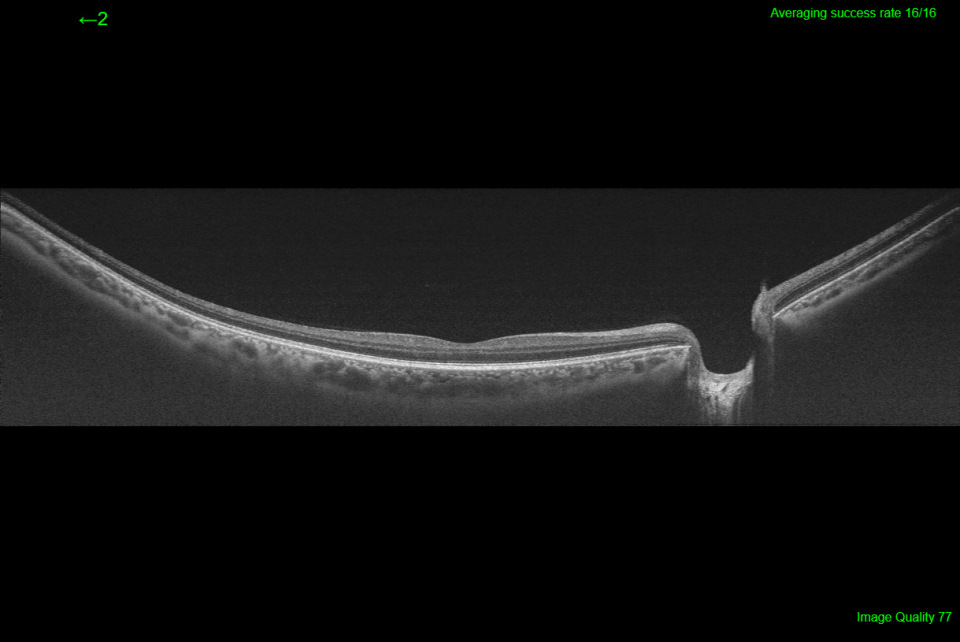
slide

Allgemein
Hauptmerkmale
- Slit-Scan Technologie: Brillante Farb-Fundusbilder auch durch kleine Pupillen (ab 2,0 mm)
- Weitwinkel OCT & OCTA: Optional bis zu 21 mm – für umfassendere klinische Einblicke
- Anterior Segment Analysefunktionen: Kammerwinkelmessung, Epithelium Mapping, Stroma Mapping
- Unsichtbare 1.050 nm Wellenlänge: Ermöglicht Patienten eine bessere Fixation und reduziert Augenbewegungen – für weniger Wiederholscans und einen reibungslosen Workflow
- Hochgeschwindigkeits-Scanning: Mit 100.000 A-Scans/Sekunde werden dichte, klare B-Scans erstellt und Bewegungsartefakte minimiert
- Smart Denoise (optional): KI-gestützte Bildoptimierung mit höherem Kontrast und weniger Bildrauschen
- Kombinations-Scan: Verknüpft 3D-Volumendaten mit hochauflösenden Linearscans in einer einzigen Aufnahme
- OCT-Angiografie (optional): Detaillierte Darstellung der Gefässstrukturen mit proprietärem OCTARA™ Algorithmus
- Follow-Up Funktion: Automatische Wiedererfassung derselben Region für präzise Verlaufsvergleiche
- Komplette Glaukom- und Vorderabschnitts-Analyse: 12×9 mm 3D Wide Scan für Sehnerv und Makula in einer Aufnahme; optionale Vorderabschnitts-Bildgebung für umfassende Diagnostik
- Flexible Bedienung & Integration: 180° drehbares Bedienpanel, Live Fundus View und nahtlose Anbindung an IMAGEnet7 (DICOM-kompatibel)
SMARTTrack aktives Eyetracking
Das SMARTTrack-System erweitert die Nutzerfreundlichkeit und die Fähigkeiten des Triton mit fundusgesteuerter Untersuchung (FGA), Follow-up-Funktion und Tracking-Fotografie.
Eine neue Dimension der OCT-Bildgebung
Das Swept-Source-OCT Triton bietet eine einzigartige Qualität in der Bildgebung des vorderen und hinteren Augenabschnitts. Mit einer beeindruckenden Brillanz sind die Strukturen von Glaskörper und Aderhaut gleichzeitig darstellbar. Dazu gibt es hochauflösende Fundusbilder, die Darstellung von Blutgefässen ohne Injektion von Kontrastmitteln und in der Variante Plus auch Fluoreszenz-Angiographie und Autofluoreszenz-Aufnahmen.
Neu mit Wide Field-Funktion